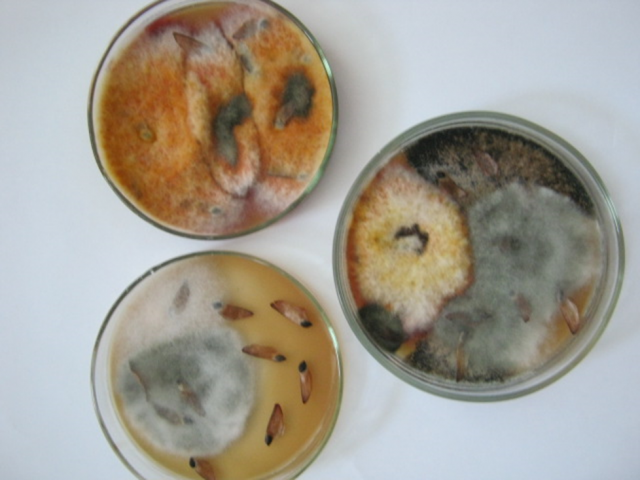

Відкрита лекція з дисципліни «Діагностика хвороб лісу»
10 квітня 2023 року відбудеться відкрита лекція з дисципліни «Діагностика хвороб лісу» для студентів денної форми навчання ОС «Магістр» спеціальності 205 «Лісове господарство». Початок 15:35 (5 пара).
Тема лекції: «МІКРОСКОПІЧНИЙ ТА БІОЛОГІЧНИЙ МЕТОДИ ДІАГНОСТИКИ ХВОРОБ ДЕРЕВНИХ РОСЛИН»
Платформа Cisco Webex – https://nules.webex.com/meet/hanna.boiko
Лектор: доцент кафедри лісівництва, канд. с.-г. наук Бойко Ганна Олексіївна